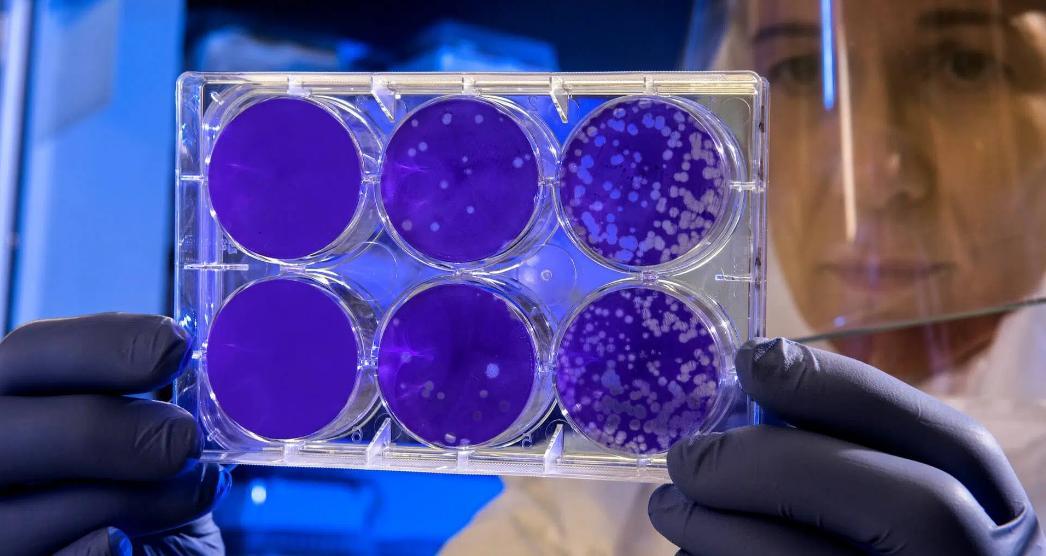

أفريقيا برس – الصحراء الغربية. تعتبر “الدفتيريا” عدوى تسببها بكتيريا الخُنَّاق الوتدية، وعادةً ما تبدأ علاماتها وأعراضها بعد يومين إلى خمسة أيام من التعرّض للبكتيريا المسببة لها وتتراوح حدتهما بين خفيفة ووخيمة.
وقالت منظمة الصحة العالمية أنه غالباً ما تظهر الأعراض تدريجياً وتبدأ بالتهاب في الحلق وحمى. وفي الحالات الوخيمة، تُنتج هذه البكتيريا سُمّاً (ذِيفاناً) يُحدث لَطْخة سميكة رمادية أو بيضاء اللون في مؤخرة الحلق. ويمكن لهذه اللطخة أن تسدّ مجرى الهواء فيصعب التنفس أو البلع، كما يمكن أن تسبب سُعالاً نُباحياً. وقد يتورّم العُنق لأسباب منها تضخّم العقد اللمفية.
وينتشر وباء “الدفتيريا” بين الأشخاص بالملامسة المباشرة أو استنشاق الرذاذ المتطاير من الشخص المصاب كالناجم عن السُّعال أو العطس.
كما يمكن أن تنتشر العدوى بملامسة الملابس أو الأشياء الملوثة بالبكتيريا.
فيا يعتمد التشخيص السريري للدفتيريا عادةً على وجود غشاء مائل إلى اللون الرمادي يغطي الحلق. ومع أنه يوصى بتحرّي الحالات المشتبه فيها مختبرياً لتأكيد وقوع الإصابة، إلا أنه ينبغي البدء فوراً في علاجها.
وتعالَج عدوى الدفتيريا بإعطاء المريض مضاداً لذيفان الدفتيريا عن طريق الوريد أو بحُقنة عضلية. ويُعطى أيضاً مضادات حيوية للقضاء على البكتيريا وإنتاجها للذيفان ومنع سريان العدوى إلى الغير.
يمكنكم متابعة المزيد من أخبار و تحليلات عن الصحراء الغربية اليوم عبر موقع أفريقيا برس